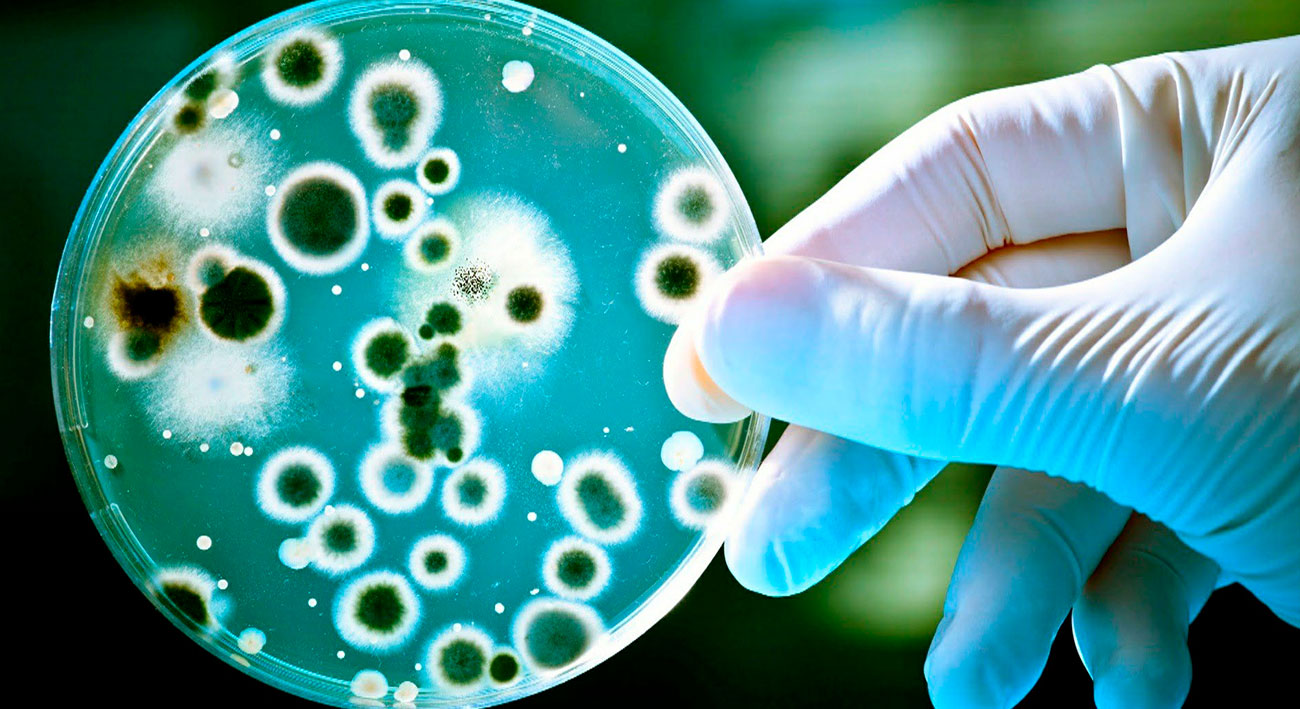

Найден способ уничтожения двойной защиты бактерий от антибиотиков
С момента открытия в 1929 году антибиотиков прошло много лет, и за это время опасные бактерии научились защищаться от своих главных убийц. У них выработались защитные механизмы, и если ученые не найдут действенные способы обойти их, человечество вновь может стать уязвимым к огромному количеству болезней. У некоторых бактерий защита состоит аж из двух слоев — благо, исследователи из Университета Томаса Джефферсона нашли способ уничтожить их за один раз.
Двумя слоями защиты, например, обладают кишечная палочка и сальмонелла. Если антибиотик и пройдет через один слой клеточной мембраны, второй слой обязательно вытолкнет его обратно. Однако, есть одна лазейка — белки, которые важны для функционирования клеток, вырабатываются транспортной РНК, изменив структуру которой можно провоцировать совершение ошибок.
Чтобы доказать это, исследователи создали инженерные штаммы кишечной палочки и сальмонеллы, лишив их транспортную РНК определенной химической части. Имея «дефектные» молекулы, бактерии не смогли выработать защитные белки, и их клеточные мембраны лишились своей сплоченности. Следовательно, через них смогло пройти больше антибиотических молекул, и бактерии умирали гораздо быстрее.
Мы доказали, что вмешательство в молекулу транспортной РНК наносит вред способности бактериальной клетки вырабатывать мембранные белки, необходимые для защиты от антибиотиков. Скорость уничтожения бактерий крайне важна — чем дольше бактерии умирают, тем больше вероятность развития резистентности.
Я-Минг Хоу, руководитель исследовательской группы
Теперь перед учеными стоит более масштабная задача — им необходимо разработать способ изменения структуры транспортной РНК. Бактерии, использованные в эксперименте, были спроектированы специально, а в природе они они по-прежнему отлично вырабатывают защитные белки.
Автор: Рамис Ганиев
Источник: hi-news.ru
